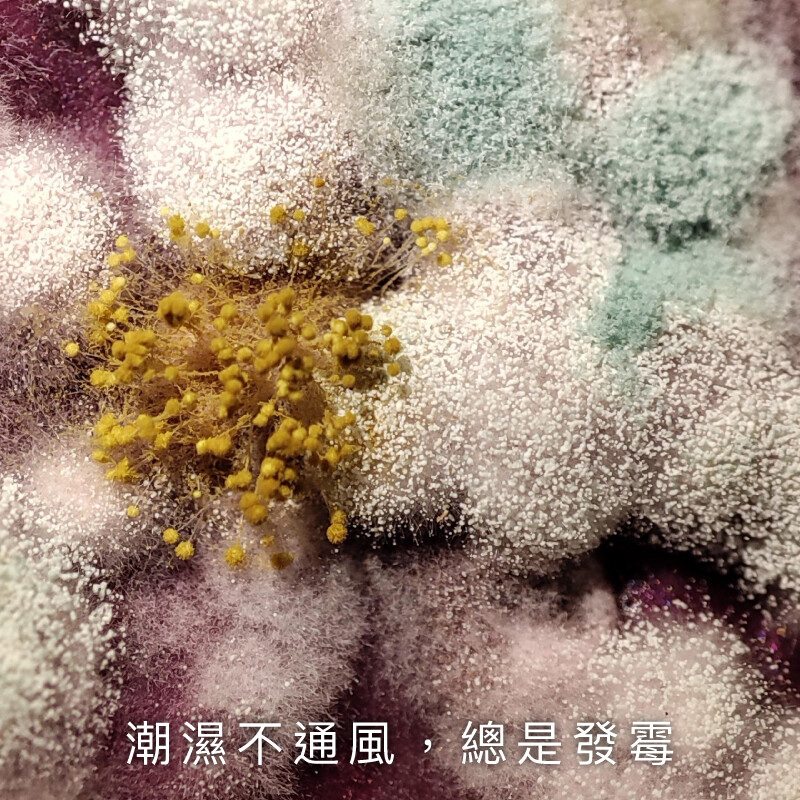

空間特工獨家研發,用更聰明的方式打造你的日常衣櫃!
這款免螺絲角鋼衣櫃搭配雙桿吊衣桿設計,上下吊掛分層,空間翻倍利用,長短衣物分類更清晰。下方層板可收納摺疊衣物、收納箱、鞋盒等物品,上方則可用來吊掛外套、襯衫或長洋裝,讓收納變得更加有條不紊。層板與吊桿皆可依需求調整高度,真正打造屬於你的模組化開放式衣櫃。
【商品特點】
• 空間特工 MIT 台灣製造,品質穩定可靠
• 免螺絲設計,安裝快速、無需工具
• 雙桿吊衣桿設計,吊掛容量翻倍,分類更直覺
• 層板與吊桿皆可自由調整位置,因應季節與收納需求變化
• 開放式設計通風不悶熱,適合衣物長期掛放
這款免螺絲角鋼衣櫃搭配雙桿吊衣桿設計,上下吊掛分層,空間翻倍利用,長短衣物分類更清晰。下方層板可收納摺疊衣物、收納箱、鞋盒等物品,上方則可用來吊掛外套、襯衫或長洋裝,讓收納變得更加有條不紊。層板與吊桿皆可依需求調整高度,真正打造屬於你的模組化開放式衣櫃。
【商品特點】
• 空間特工 MIT 台灣製造,品質穩定可靠
• 免螺絲設計,安裝快速、無需工具
• 雙桿吊衣桿設計,吊掛容量翻倍,分類更直覺
• 層板與吊桿皆可自由調整位置,因應季節與收納需求變化
• 開放式設計通風不悶熱,適合衣物長期掛放